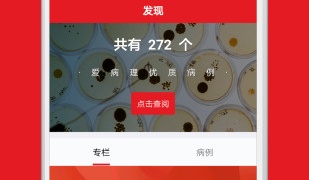
病历生成器APP

病历生成器APP
病历生成器手机app合集是小编为用户收录好用手机app汇编带来,用户可以通过本合集快速找到自己需要的手机app,而且搜索便利,下载安全快速,同时小编还会实时更新给用户带来更多好用的手机app!
更新时间:2023-08-10
病历生成器手机app合集是小编为用户收录好用手机app汇编带来,用户可以通过本合集快速找到自己需要的手机app,而且搜索便利,下载安全快速,同时小编还会实时更新给用户带来更多好用的手机app!
违法和不良信息举报邮箱:1548127136@qq.com
版权投诉与合作邮箱:1548127136@qq.com
版权所有Copyright © 2021-2026 7yz.com 七叶子游戏 All Rights Reserved